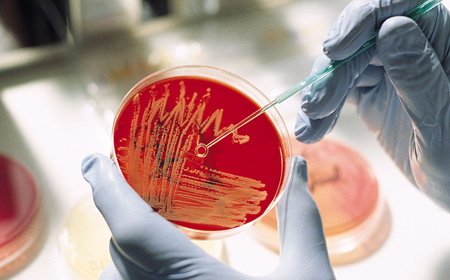

Hilfe auf zweifache Weise
Zentrales Anliegen der Welt-Arthrose-Organisation ist es, allen Arthrosebetroffenen das wissenschaftlich fundierte, gesicherte Wissen über Arthrose zugänglich zu machen.
Forschung
Arthroseforschung ist eine der edelsten Formen der Hilfe. Auf neue Behandlungsmethoden setzen viele Betroffene große Hoffnung. Besonders wer unter Arthrose an mehreren Gelenken gleichzeitig leidet, hofft zutiefst auf baldige Erfolge, die die Beschwerden vermindern oder – mehr noch – die Arthrose einmal ganz heilen können.
Hilfreicher Rat
Hilfreiche Informationen und praktischen Rat bündeln wir in den Arthrose-Info-Heften.
Diese wichtigen Publikationen erscheinen 4 x im Jahr und ermöglichen Ihnen:
- das Lernen von den besten Experten
(praktische Tipps auf wissenschaftlicher Basis)
- kostbaren Austausch mit anderen Arthrosebetroffenen und Lernen von deren Erfahrungen


